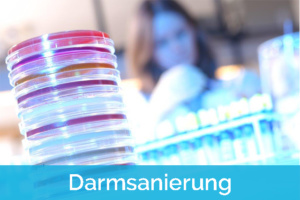

GANZHEITLICHE NATURHEILPRAXIS IN HAMBURG UHLENHORST
Körper
Die ganzheitliche Behandlung Ihrer körperlichen Leiden steht in unserem Therapiezentrum stets im Mittelpunkt. Beschwerden des Bewegungsapparates gehen auf die tiefen Strukturen des menschlichen Körpers zurück. Dort müssen sie auch behandelt werden. Lassen Sie Ihre Faszien mit Rolfing befreien und regen Sie Ihre Selbstheilung mit Osteopathie und Akupunktur an.
Psyche
Die Psyche des Menschen ist tief und oft unergründlich. Ängste, Blockaden, wiederkehrende Muster und psychosomatische Leiden können durch traumatische Ereignisse entstanden sein. Lassen Sie uns beim ausdrucksorientierten oder Achtsamkeitscoaching, der Arbeit mit dem Inneren Kind oder einer Hypnosetherapie gemeinsam daran arbeiten oder die passende Methode für Ihre individuelle Situation finden.
Naturheilkunde
Die Naturheilkunde ist eine der ältesten Heilmethoden. Aus ihr ist die moderne Fachmedizin entstanden und sind vielfältige Therapieformen hervorgegangen. Die Natur hält Vieles für eine erfolgreiche Genesung bereit. Daran glauben wir. Lernen Sie in unserem Therapiezentrum Dunkelfeld Diagnostik, Darmsanierung und vielen anderen Methoden kennen.
EIN ZENTRUM FÜR IHRE GESUNDHEIT
Ausgewähltes Therapeutenteam
Um uns bestmöglich um Ihr Wohlbefinden kümmern zu können, treffen Sie in unserem Therapiezentrum ausschließlich auf Spezialisten. Hohe und sich ausgezeichnet ergänzende Qualifikationen sowie ein harmonisches Miteinander prägen unser Therapeutenteam.
Einladende Räume
Wir heißen Sie in unseren offenen, hellen Räumen in Hamburg Uhlenhorst willkommen! Entfliehen Sie für die Zeit Ihres Besuches der schnelllebigen Großstadt und fühlen Sie sich in unserer Praxis und in unseren Händen wohl und geborgen.
Alles unter einem Dach
Gesundheit besteht aus vielen Facetten. Damit auch in Ihrem Fall Heilung entstehen kann, treffen Sie in unserer Gemeinschaftspraxis auf eine Vielzahl an Therapiemöglichkeiten und erfahrenen Profis – alles an einem Ort.
UNSERE THERAPEUTEN
Angelique Rode
Heilpraktikerin für Psychotherapie, Psychologie B.Sc.
Marc Kirschstein
Heilpraktiker, Certified Rolfer®, Mikronährstoff-Coach
Gwendolin Taube
Osteopathin B.Sc., Körperpsychotherapeutin, Heilpraktikerin
Iris Brauner
Heilpraktikerin
Annette Ehlert
Heilpraktikerin für Psychotherapie, Psychoonkologin und Trauerbegleiterin
Elena Markova
Longevity / Prävention / Bioresonanz
Angelika
Luck-von Hassel
Heilpraktikerin, Energetikerin, Dipl. Sozialpädagogin
Nina Gerber
Heilpraktikerin, Körpertherapeutin
UNSER THERAPIEANGEBOT
- Zeige alle
- Körper
- Naturheilkunde
- Psyche